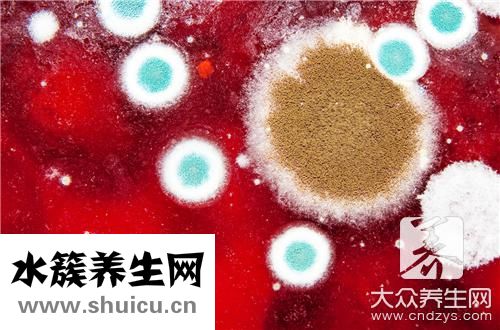
墻面發霉

據了解,如果你的居住環境太潮濕,墻面會非常容易達到發霉,對人體健康非常不利,甚至可能會導致風濕病。 在墻面發霉中,請注意環境的清潔,保持居住環境的干燥衛生,根據需要使用除霉菌劑等。 那么,墻面發霉對人體有害嗎?

首先你得知道,墻壁發霉一般是由潮濕引起的,如果人體長期生活在潮濕的環境下,人是會得風濕病的。而且發霉的墻體霉菌滋生,會造成室內的細菌含量過高,引發人體對霉菌孢子的過敏,人體長期呼吸時吸入太多的話,很容易造成呼吸道疾病,有些朋友甚至會造成窒息。
墻壁發霉了該怎么處理
輕微霉斑的處理
1、在抹布上沾上除霉劑、84消毒液或是漂白水溶劑來擦拭發霉的墻面,或者用小噴壺霧化后再進行噴灑,把霉斑清理干凈。
2、等過了24小時之后,用干凈的抹布沾上清水擰干之后再擦拭一遍(發霉嚴重的情況可重復操作一次),注意保持墻面的干燥,避免再次發霉。
嚴重霉斑的處理
1、先用砂紙、鏟刀把霉斑鏟除掉,再用除霉劑、84消毒液或漂白水溶液對墻面進行噴灑。
2、用膩子將墻面修補平整,長期潮濕的墻面應做防水層處理(此前應查找并修補墻體可能存在的滲漏水現象);
3、等到膩子層干透后刷涂封閉底漆、防霉加強型抗堿底漆;
4、最后在墻面上刷涂一層防霉面漆。
墻壁發霉房間防潮很關鍵
使用除濕劑
墻體潮濕發霉的話,可以去使用干燥劑、活性炭進行防潮、吸濕。超市里有不少專用來防潮除濕的干燥劑,最常見的就是吸濕盒和除濕包了。
使用空氣吸濕器
它就像吸塵器一樣,可以把墻壁發霉潮濕的空氣集中在一起,等到濕氣很多時候就會變成水。利用空調除濕。家庭使用的空調一般都有除濕的功能,不過,空調來調節室內空氣濕度的方式見效較慢,一般需要兩三個鐘頭,而且會使室內的人感到寒冷。
利用石灰、竹炭除濕
用小布袋裝適量石灰,扎成一小袋放置于室內的各個角落,石灰本身有吸潮的作用,也可以減緩墻回潮發霉的狀況,同時,石灰還有消毒功效,一舉兩得。竹炭除濕,可以反復使用,但是得多用,少了效果不怎么好。

在外界濕氣重的時候應關門窗,防濕防潮
平時應多開窗通風透氣,來降低室內水蒸氣含量。特別是剛裝修完的新房子,水汽特別大,更要多通風透氣,以將濕氣清除。
選擇家具時,希望表達自己的品味,提高自己的生活質量。 一級上的家具不僅讓大家感到非常舒適,也有助于大家的健康。 很多人選擇使用樹脂家具,使房子看起來很高級,而且房子看起來干凈舒適。 那么,樹脂家...
瑪瑙是很多女性喜歡的寶石,除了純天然的瑪瑙外,女性還非常喜歡染色瑪瑙。 染色瑪瑙是指對瑪瑙進行染色處理,使瑪瑙呈現不同的顏色。 染色瑪瑙可以加溫染色,也可以是染料染色,但也有人擔心染色瑪瑙對身...
銅是存在于自然中的一種金屬,黃銅最主要的用途是用于幾種電線。 因為黃銅的導電功能非常好。 另外,在一些醫學中,黃銅也作為醫用藥劑進行,特別是對于一些感染性情況,黃銅具有較強的治愈效果。 一般人...
大多數患有動脈和靜脈血栓的人會成為抗磷脂綜合征的患者。 這些人免疫系統功能不全,容易感染細菌,抗磷脂綜合征能治好嗎? 雖然現在也有治愈的數據,但是每個人的身體狀況都不一樣,并不是所有患有這種病...
韭菜黃瓜的組合在飲食中很常見。 這兩種食物具有互補的特性,不僅在營養方面互補,而且在味道方面有很強的互補,搭配的菜肴味道更濃更好吃。 例如,做韭菜黃瓜餃子非常適合。 看看韭菜黃瓜餃子餡的做法...
選擇耳機時,多選自入耳式和耳塞式兩種型式,入耳式耳機在普通耳機的基礎上,用膠塞頭插入耳道內,獲得更好的密閉性。 耳機的表現效果大幅增加,這種密閉性強,可以沉浸在音樂的海洋中。 不要被外面的世界打...
很多人非常在意自己的皮膚狀態,但是如果皮膚長得很好,也要重視閉口。 這種情況下,很可能是皮膚干燥和內分泌紊亂造成的,當然也要注意化妝品的使用。 (2) 0且長)1) 0重復時,必須想辦法避免亂涂藥物,才能...
4個月的小寶寶,必須有足夠的睡眠。 良好的睡眠能促進寶寶的身體發育,且有利于寶寶的身心健康。 寶寶睡眠長期不好會引起一系列危害。 如果發現寶寶睡眠...
所有父母都不想生畸形的孩子,但是一旦寶寶出生就畸形,幾乎很難治愈,對整個家庭都會造成很大的危害。 因此,對嬰兒畸形最重要的應對措施是采取預防措施。 因此,女性們懷孕后,需要在醫院做排畸檢查這個檢...
想快速懷孕的女性們,認真計算自己的排卵日,一到排卵日就和丈夫抽出時間同房。 因為此時同房懷孕概率最高,為了提高成功率,很多夫婦此時會頻繁同房,連續&0,以免錯過排卵期...
硒是人體的生命之火,是人體內不可缺少的營養成分,生活中很多水果都含有硒元素,但你知道含硒第一名的水果是什么嗎?含硒高的水果又有哪些呢?跟水簇養生網一起來看看吧。...
一級夫妻性生活的年紀大概在20歲到50歲左右,如果是一種比較好的情況下,性生活的頻率一般在10到20分鐘左右,如果是比較差的夫妻,性生活的頻率可能會受到很多因素的影響,有些人可能會擔心,性生活的質量不...
黃ba等中草藥可用于治療多種男科疾病。 可是不應過多使用。 畢竟,該藥具有三點毒性,并且肯定會引起身體某些副作用,尤其是對腎功能的影響,將產生非常大的影響,因此一定應該引起注意, 可能會繼續導致自...
三道鱗魚是歐美鯽魚的一種變異魚,它在人體表面的鱗片很大。所以在歐洲的一些地區,經常有人用三道鱗魚來曬蝦米作為鏡子,所以三道鱗魚也有另外一個名字,鏡魚。如今,三道鱗魚已經被引入中國許多地區進行...
在我們的日常生活中,桂花酒屬于一種常見的酒,具有桂花樹的香味和多種營養元素,特別適合冬季飲用。桂花酒可以暖身祛寒作用,還可以合理減少疲勞功效,改善睡眠質量等。...
許多人喜歡在冬天去釣魚。在這種情況下,米酒通常被用作巢的材料。對于一些更有經驗的人來說,筑巢是非常好的。然而,許多人沒有做好并死去。死亡巢穴的出現有很多原因。可能是制作巢料時香料的味道太...
三角肌 注射是預防接種醫院門診的重點工作。精確定位和選擇合適的位置對于確保安全注射非常重要。三角肌注射/的正確方式是什么?三角肌宜注射方法是將右手收緊在部分皮膚上,將無名指固定在針上,使針...
我堅信很多人都吃過馬鮫魚,這是一種有價值的魚,營養含量很高,比如蛋白質豐富多彩。另外,馬鮫魚含有維生素A和各種礦物質元素。據了解,食用馬鮫魚具有補氣養血的功效,還具有止咳化痰的功效。女性可以通...
夏天很多人喜歡買泥鰍吃。泥鰍有很多做法,比如蒸、炸等等。它是一種人們非常喜歡吃的食物。而且泥鰍的營養價值也很高,但是每次吃的時候處理掉泥鰍是個麻煩的問題,尤其是如果內臟需要清理的話。所以...
相信很多人都用過上海藥皂,它是中國上海第一塊特效除菌皂,那么上海藥皂都有什么作用呢?下面就來說說上海藥皂的功效與作用,一起來了解下吧。...